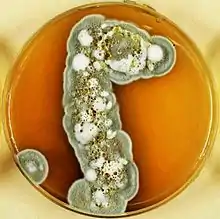

| Pseudogymnoascus destructans | |
|---|---|
![]() | |
| In white nose syndrome, Pseudogymnoascus destructans can be found growing on the muzzle, wing, and ear of bats, in this case, a little brown bat. | |
| Scientific classification | |
| Domain: | Eukaryota |
| Kingdom: | Fungi |
| Division: | Ascomycota |
| Class: | Leotiomycetes |
| Order: | Thelebolales |
| Family: | Pseudeurotiaceae |
| Genus: | Pseudogymnoascus |
| Species: | P. destrucans |
| Binomial name | |
| Pseudogymnoascus destrucans (Blehert & Gargas) Minnis & D. L. Lindner | |
| Synonyms | |
| |
Pseudogymnoascus destructans (formerly known as Geomyces destructans) is a psychrophilic (cold-loving) fungus that causes white-nose syndrome (WNS), a fatal disease that has devastated bat populations in parts of the United States and Canada. Unlike species of Geomyces, P. destructans forms asymmetrically curved conidia.[1] Pseudogymnoascus destructans grows very slowly on artificial media and cannot grow at temperatures above 20 °C.[1][2][3] It can grow around 4 °C to 20 °C, which encompasses the temperatures found in winter bat hibernacula.[1][2] Phylogenic evaluation has revealed this organism should be reclassified under the family Pseudeurotiaceae, changing its name to Pseudogymnoascus destructans.[4]
History
In 2008, Blehert et al. described the fungus associated with white-nose syndrome as a member of the genus Geomyces.[5] In 2009, Gargas et al. were the first to describe the fungus as a unique species; the specific name they chose, "destructans", means "destroying".[1] The fungus was definitively identified as the cause of the syndrome in bats, according to research published in 2011 by scientists at the United States Geological Survey.[6] It was previously unknown whether this fungus was the primary cause of WNS or was an opportunistic pathogen associated with the disease, though strong evidence suggested that the fungus was the etiologic agent.[2][7] In 2013, an analysis of the phylogenetic relationship indicated that this fungus was more closely related to the genus Pseudogymnoascus than to the genus Geomyces changing its Latin binomial to Pseudogymnoascus destructans.[4]
Distribution
Pseudogymnoascus destructans is believed to originate from Europe.[4][8] The current P. destructans European distribution includes Austria, Belgium, Czech Republic, Denmark, Estonia, France, Germany, Hungary, the Netherlands, Poland, Romania, Slovakia, Switzerland, Turkey, Ukraine and the United Kingdom.[7][8][9][10]
The North American geographic distribution of P. destructans continues to increase each year since its initial introduction to New York State in 2006. Its current distribution includes 38 states in the U.S.A. and at least 7 Canadian provinces.
Bat species affected by P. destructans
In North America, P. destructans has been found to infect at least eleven species of bats,[11] of which it has caused diagnostic symptoms of white-nose syndrome in the endangered Indiana bat (Myotis sodalis), the endangered gray bat (Myotis grisescens), the endangered little brown bat (Myotis lucifugus), the northern long-eared bat (Myotis septentrionalis), the big brown bat (Eptesicus fuscus), the tri-colored bat (Perimyotis subflavus), and the eastern small-footed bat (Myotis leibii).[1][12] Pseudogymnoascus destructans has been found on four additional North American bat species: the endangered Virginia big-eared bat (Corynorhinus townsendii virginianus), the cave bat (Myotis velifer), the Silver-haired bat (Lasionycteris noctivagans), and the South-eastern bat (Myotis austroriparius). The European bat species that have been shown to harbour P. destructans include Bechstein's bat (Myotis bechsteinii), Lesser mouse-eared bat (Myotis blythii oxygnathus), Brandt's bat (Myotis brandtii), pond bat (Myotis dasycneme), Daubenton's bat (Myotis daubentonii), Greater mouse-eared bat (Myotis myotis), whiskered bat (Myotis mystacinus), Geoffroy's bat (Myotis emarginatus), Northern bat (Eptesicus nilssonii), Lesser horseshoe bat (Rhinolophus hipposideros), Barbastell (Barbastella barbastellus), Brown long-eared bat (Plecotus auritus) and Natterer's bat (Myotis nattereri), although large-scale European bat related fatalities are not reported.[9][13]
Biology

P. destructans is a psychrophilic fungus, able to grow below 10 °C (50 °F) and with an upper limit near 20 °C (68 °F). This fungus produces brown and grey colonies, secretes a brownish pigment and reproduces asexually via characteristically curved conidia when cultured on Sabaouraud dextrose agar. The asymmetrically curved conidia are produced at the tips or sides singly or in short chains. Arthroconidia can be present and undergo rhexolytic separation.[1] Research has shown that P. destructans grows optimally between 12.5 and 15.8 °C (54.5 and 60.4 °F), with an upper growth limit of about 20 °C (68 °F).[3] The in vitro growth rate of P. destructans is reported to be very slow; however, several studies have shown that not all P. destructans isolates grow at the same rate.[3][14] P. destructans grows as an opportunistic pathogen on bats, causing white-nose syndrome,[1] but it can also persist in the cave environment,[15] as a saprotroph.[16][17] P. destructans can grow and sporulate (reproduce asexually via conidiation) on keratinaceous, chitinaceous, cellulosic, and lipid/protein rich substrates including dead fish, mushroom fruit bodies and dead insects.[16] P. destructans has been shown to utilize many nitrogen sources: nitrate, nitrite, ammonium, urea, and uric acid.[16] Although P. destructans can penetrate senescing moss cells,[18] cellulosic debris may not be a long term substrate for colonization.[16] P. destructans can tolerate elevated levels of environmental inhibitory sulfur compounds (cysteine, sulfite, and sulfide), grow over a wide pH range (pH 5-11), tolerate elevated environmental levels of calcium; however, P. destructans was found to be intolerant to matric-induced water stress.
Enzymatic activity

Under laboratory conditions, P. destructans has been shown to produce numerous enzymes including β-glucosidase, esterase/esterase lipase/lipase, leucine and valine arylamidase, N-acetyl-β-glucosaminidase, naphthol-AS-B1-phosphohydrolase, both acid and alkaline phosphatases, various proteinase, and urease, while testing negative for cystine arylamidase, α-chymotrypsin, alpha/beta-galactosidase, β-glucuronidase, α-fucosidase, α-mannosidase, and trypsin.[2] Important dual virulence factors found in P. destructans and many other pathogenic fungi include urease, proteinase (aspartyll) and superoxide dismutase.[18][19]
Control agents
In 2011, several compounds (antifungals, fungicides, and biocides) where shown to effectively inhibit the growth of P. destructans including benzalkonium chloride, chloroacetoxyquinoline, chloroxine, ciclopirox olamine, econazole, phenylmercuric acetate, pyrithione zinc and sulconazole.[20] The same study showed that P. destructans was sensitive to Amphotericin B, itraconazole, ketoconazole, posaconazole and voriconazole, while the fungus had some resistance to anidulafungin, caspofungin, flucytosine and micafungin. A recent study (2014) identified several volatile organic compounds (benzaldehyde, benzothiazole, decanal, nonanal, N,N-dimethyloctylamine, and 2-ethyl-1-hexanol) that were previously identified from fungistatic soils, which demonstrated inhibition of both mycelial extension and growth from conidia.[21]
A 2015 study showed that Rhodococcus rhodochrous could inhibit the growth of P. destructans.[22]
A positive breakthrough may have come while utilizing competitive genetics to investigate the evolutionary history of P. destructans compared to six closely related nonpathogenic species. The study published in the journal Nature Communications in 2018 discovered that due to a lost enzyme, P. destructans lacks an ability to repair DNA which has been damaged by ultraviolet (UV) light.[23] Ongoing research is taking place to see if there is a practical method to have bats activate a UV system as they enter and leave a hibernaculum and treat their infection. Not a long term solution, it may be enough to avoid population collapse allowing the species to evolve its own defenses to the fungus as Eurasian bats have.
References
- 1 2 3 4 5 6 7 Gargas A, Trest MT, Christensen M, Volk TJ, Blehert DS (April–June 2009). "Geomyces destructans sp. nov. associated with bat white-nose syndrome" (PDF). Mycotaxon. 108: 147–154. doi:10.5248/108.147. Archived from the original (PDF) on 2012-09-15. Retrieved 2010-12-30.
- 1 2 3 4 Chaturvedi V, Springer DJ, Behr MJ, Ramani R, Li X, Peck MK, Ren P, Bopp DJ, Wood B, Samsonoff WA, Butchkoski CM, Hicks AC, Stone WB, Rudd RJ, Chaturvedi S (May 2010). "Morphological and Molecular Characterizations of Psychrophilic Fungus Geomyces destructans from New York Bats with White Nose Syndrome (WNS)". PLOS ONE. 5 (5): e10783. Bibcode:2010PLoSO...510783C. doi:10.1371/journal.pone.0010783. PMC 2875398. PMID 20520731.
- 1 2 3 Verant ML, Boyles JG, Waldrop W, Wibbelt G, Blehart DS (September 2012). "Temperature-dependent growth of Geomyces destructans, the fungus that causes bat white-nose syndrome". PLOS ONE. 7 (9): e46280. Bibcode:2012PLoSO...746280V. doi:10.1371/journal.pone.0046280. PMC 3460873. PMID 23029462.
- 1 2 3 Minnis AM, Lindner DL (July 2013). "Phylogenetic evaluation of Geomyces and allies reveals no close relatives of Pseudogymnoascus destructans, comb. nov., in bat hibernacula of eastern North America". Fungal Biology. 117 (9): 638–49. doi:10.1016/j.funbio.2013.07.001. PMID 24012303.
- ↑ Blehert DS, Hicks AC, Behr M, et al. (October 2008). "Bat White-Nose Syndrome: An Emerging Fungal Pathogen?". Science. 323 (5911): 227. doi:10.1126/science.1163874. PMID 18974316. S2CID 23869393.
- ↑ Lorch, Jeffrey M.; Meteyer, Behr; Boyles, Cryan; Hicks, Ballman; Coleman, Redell; Reeder, Blehert (2011-10-26). "Experimental infection of bats with Geomyces destructans causes white-nose syndrome". Nature. advanced online publication (7377): 376–378. Bibcode:2011Natur.480..376L. doi:10.1038/nature10590. PMID 22031324. S2CID 4381156.
- 1 2 Puechmaille, Sébastien J.; Verdeyroux, Pascal; Fuller, Hubert; Ar Gouilh, Meriadeg; Bekaert, Michaël; Teeling, Emma C (February 2010). "White-nose syndrome fungus (Geomyces destructans) in bat, France". Emerging Infectious Diseases. Atlanta: Centers for Disease Control and Prevention. 16 (2): 290–293. doi:10.3201/eid1602.091391. ISSN 1080-6059. PMC 2958029. PMID 20113562.
- 1 2 Puechmaille, SJ; Wibbelt G; Korn V; Fuller H; Forget F.; et al. (2011). "Pan-European distribution of white-nose syndrome fungus (Geomyces destructans) not associated with mass mortality". PLOS ONE. 6 (4): e19167. Bibcode:2011PLoSO...619167P. doi:10.1371/journal.pone.0019167. PMC 3083413. PMID 21556356.
- 1 2 Martinkova, N; Backer P; Bartonicka T; Blazkova P; Cerveny J; et al. (2010). "Increasing incidence of Geomyces destructans fungus in bats from Czech Republic and Slovakia". PLOS ONE. 5 (11): e13853. Bibcode:2010PLoSO...513853M. doi:10.1371/journal.pone.0013853. PMC 2974652. PMID 21079781.
- ↑ Wibbelt G, Kurth A, Hellmann D, Weishaar M, Barlow A, et al. (2010). "White-nose syndrome fungus (Geomyces destructans) in bats, Europe". Emerging Infectious Diseases. 16 (8): 1237–1242. doi:10.3201/eid1608.100002. PMC 3298319. PMID 20678317.
- ↑ "Bats affected by WNS / White Nose Syndrome". whitenosesyndrome.org. U.S. Fish and Wildlife Service. Retrieved February 17, 2018.
- ↑ Blehart, DS; Hicks AC; Behr M; et al. (October 2008). "Bat white-nose syndrome: an emerging fungal Pathogen?". Science. 323 (5911): 227. doi:10.1126/science.1163874. PMID 18974316. S2CID 23869393.
- ↑ Zukal J, Bandouchova H, Bartonicka T, Berkova H, Brack V, Brichta J, Dolinay M, Jaron KS, Kovacova V, Kovarik M, Martínková N, Ondracek K, Rehak Z, Turner GG, Pikula J (May 2014). "White-nose syndrome fungus: a generalist pathogen of hibernating bats". PLOS ONE. 9 (5): e97224. Bibcode:2014PLoSO...997224Z. doi:10.1371/journal.pone.0097224. PMC 4018256. PMID 24820101.
- ↑ Johnson L, Miller AN, McCleery RA, McClanahan R, Kath JA, Lueschow S, Porras-Alfaro A (June 2013). "Psychrophilic and psychrotolerant fungi on bats and the presence of Geomyces spp. on bat wings prior to the arrival of white nose syndrome". Applied and Environmental Microbiology. 79 (18): 5465–5471. Bibcode:2013ApEnM..79.5465J. doi:10.1128/AEM.01429-13. PMC 3754168. PMID 23811520.
- ↑ Lorch, JM; Muller LK; Russell RF; O'Connor M; Lindner DL; Blehert DS (2013). "Distribution and environmental persistence of the causative agent of white-nose syndrome, Geomyces destructans, in bat hibernacula of the eastern United states". Applied and Environmental Microbiology. 79 (4): 1293–1301. Bibcode:2013ApEnM..79.1293L. doi:10.1128/AEM.02939-12. PMC 3568617. PMID 23241985.
- 1 2 3 4 Raudabaugh, DB; Miller AN (2013). "Nutritional capability of and substrate suitability for Pseudogymnoascus destructans, the causal agent of bat white nose syndrome". PLOS ONE. 8 (10): e78300. Bibcode:2013PLoSO...878300R. doi:10.1371/journal.pone.0078300. PMC 3804546. PMID 24205191.
- ↑ Reynolds, HT; Barton HA (2014). "Comparison of the white-nose syndrome agent Pseudogymnoascus destructans to cave dwelling relatives suggests reduced saprotrophic enzyme activity". PLOS ONE. 9 (1): e86437. Bibcode:2014PLoSO...986437R. doi:10.1371/journal.pone.0086437. PMC 3899275. PMID 24466096.
- 1 2 Smyth, CS; Schlesinger SC; Overton BE; Butchkoshi C (2013). "The alternative host hypothesis and potential virulence genes in Geomyces destructans". Bat Research News. 54: 17–24.
- ↑ Casadevall, A; Steenbergen JN; Nosanchuk JD (2003). "'Ready made' virulence and 'dual use' virulence factors in pathogenic environmental fungi-the Cryptococcus neoformans paradigm". Current Opinion in Microbiology. 6 (4): 332–337. doi:10.1016/s1369-5274(03)00082-1. PMID 12941400.
- ↑ Chaturvedi, S; Rajkumar SS; Li X; Hurteau GJ; Shtutman M; Chaturvedi V (2011). "Anti fungal testing and high-throughput screening of compound library against Geomyces destructans, the etiologic agent of geomycosis (WNS) in bats". PLOS ONE. 6 (3): e17032. Bibcode:2011PLoSO...617032C. doi:10.1371/journal.pone.0017032. PMC 3047530. PMID 21399675.
- ↑ Cornelison, CT; Gabriel KT; Barlament C; Crow SA (2014). "Inhibition of Pseudogymnoascus destructans growth from conidia and mycelial extension by bacterially produced volatile organic compounds". Mycopathologia. 177 (1–2): 1–10. doi:10.1007/s11046-013-9716-2. PMID 24190516. S2CID 15726620.
- ↑ "Bats Successfully Treated for White-Nose Syndrome Released Back into the Wild". The Nature Conservancy. 2015-05-20. Archived from the original on 2015-05-25. Retrieved 2015-05-26.
- ↑ Lindner, Daniel L.; Foster, Jeffrey T.; Drees, Kevin P.; Palmer, Jonathan M. (2018-01-02). "Extreme sensitivity to ultraviolet light in the fungal pathogen causing white-nose syndrome of bats". Nature Communications. 9 (1): 35. Bibcode:2018NatCo...9...35P. doi:10.1038/s41467-017-02441-z. ISSN 2041-1723. PMC 5750222. PMID 29295979.
.jpg.webp)